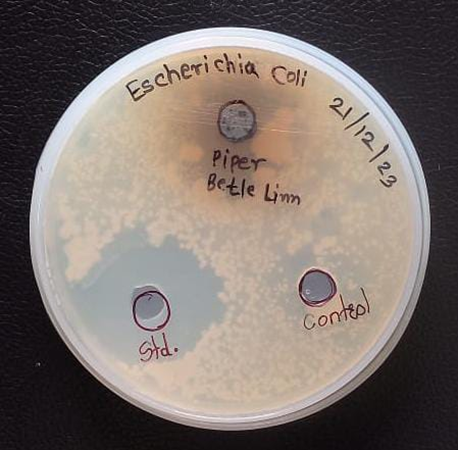

Piper betle Linn, a flowering plant species, is classified under the Piperaceae family. This climbing plant is native to various regions including India, Sri Lanka, Indonesia, and Malaysia. It features perennial, shiny leaves that are shaped like hearts. It Locally known leaves consumed its use in Ayurvedic Medicine (paan). Betel plants are grown primarily for their foliage, which is predominantly utilized as a chewing substance and breath freshener, with its main purpose being to impart flavor. Additionally, the leaves can be incorporated into culinary preparations, typically in their uncooked state, to provide a spicy taste. In the present research phytochemicals were extracted by using the Soxhlet extraction Method. The ethanolic extract of 'Piper betel Linn' was produced through six rounds of Soxhlet extraction using ethanol as the extracting agent. In Plant extract contains organic compounds such as steroids, Triterpenoids, Glucosides, protein. Piper betle Linn shows Antioxidant, Anti-Inflammatory, Antimicrobial, Antifungal, Antihelminthic, and Antibiofilm properties piper betle Linn has various health benefits and has great potential to Inhibit oxidants and biofilm and cure various Infections such as fungal and Microbial the Research Study Aims to investigate various phytochemicals and various Pharmacological Activities.
Phytochemical, Pharmacological, Antimicrobial Effects, Piper Betle Linn.
The leaves of Piper betle Linn, commonly known as Betel, serve as rich sources for novel pharmaceutical compounds. In India, these leaves have been utilized as a component of traditional medicine for generations (Subash Kumar et al.,2013). Piper betle Linn, commonly known as 'paan', is a member of the Piperaceae family. This dioecious vine can reach up to one meter in height and climbs using numerous small, unplanned rootlets. The plant thrives in warmer, more humid regions of the country (Vandana Dwivedi et al., 2014). The plant contains numerous biologically active compounds in varying concentrations, which are influenced by factors such as the plant variety, time of year, and environmental conditions. This substance is utilized in various medicinal preparations for treating wounds, burns, impetigo, furunculosis, eczema, and lymphangitis. The juice extracted from betel leaf is considered a beneficial stomachic and is effective in treating urticaria. According to Ayurvedic medicine, it helps restore balance among the three humors Vata, Pitta, and Kapha (Vandana Dwivedi et al., 2014). The pharmacological profile has shown antiplatelet, anti-inflammatory, Antibiofilm, Anticancer, antiallergic, antidiabetic, Antifungal, Antibacterial Antifertility, Antihyperglycemic, Antidermatophytic, Antinociceptive. ete (Sushma Kumar et al., 2020; Grouhar Shak et al., 2015). The foliage is utilized to treat stomach and respiratory ailments in young patients, as well as applied to infected sores (Parthasarathi et al., 2018). The Piper betle leaf is rich in phytochemicals and secondary metabolites. It contains considerable quantities of flavonoids and polyphenols. The leaf's properties are attributed to the presence of essential oils composed of phenols and terpenes. Among the terpenes found in betel are 1,8-cineole, cadinene, Caryophyllene, camphene, limonene, and pinene (Sushma Kumar et al., 2020). Researchers have extensively explored various extraction methods to obtain valuable compounds from natural sources. Among these techniques, the Soxhlet extraction method stands out as a conventional approach that has been widely employed to investigate the efficacy of extraction processes (S.E Abah et al., 2011). Piper betle Linn contains various chemical components, including Piperol-A, Piperol-B, and methyl Piper betlol. The plant also features an essential oil comprised of several compounds. These include allylpyrocortecholmonaacetate, terpinen-4-ol, Safrole, eugenol, eugenyl acetate, hydroxyl chavicol, eugenol, and piper betol. Additionally, the oil's primary constituents are caryophyllene, chavibetol, cineole, and estragole (Nishant Patel et al., 2019). Analysis of newly harvested foliage revealed the presence of various nutrients, including proteins (3-3.5%), carbohydrates (0.5-6.1%), Fiber (2.3%), minerals (2.3-3.3%), and fats (0.4-1.0%). The leaves were also found to contain several vitamins, such as nicotinic acid, vitamin A, vitamin C, thiamine, and riboflavin. Additionally, the foliage was determined to be abundant in enzymes, particularly diastase and catalase (Sushma Kumar et al., 2020). this Research Aims to inspect the phytochemical and pharmacological assets of the plant known as "piper betle Linn". this study examined the phytochemicals found in piper betle Linn. These phytochemical substances Responsible for the plants Purported medicinal benefits Were Identified. The number of extracts obtained by solvent extraction from these plants contains steroids, Triterpenoids, Glycosides, flavonoids, proteins.
2. MATERIAL AND METHODS:
2.1 Plant Collection
'Piper betle Linn' leaves were obtained from Sangli, Maharashtra, India. The collected leaves were cleansed using distilled water and subsequently dehydrated in a hot air oven at 40°C. After drying, the leaves were pulverized into a fine powder using a grinding device. This powdered material was then utilized for subsequent phytochemical analysis and pharmacological investigation.
2.2 Preparation of Piper betle L. Extract
the Soxhlet apparatus was set up, 5 gm powder was measured and placed into a thimble. sample filled thimble it was Positioned in the extraction column of Soxhlet Apparatus. A volume of 300 ml of ethanol was poured into the flask. Heating was initiated on a heating mantle attached to the Soxhlet apparatus. The extraction procedure was conducted for six cycles. The resulting extract was collected from the assembly and any remaining ethanol was evaporated using the Heating Mantle. the extract was then stored a refrigerator od 4°C.
2.3. Qualitative phytochemicals analysis
2.3.1 Examination for Glycosides
a. Keller-Kilani test
To detect the presence of cardiac glycosides, a test was conducted. The procedure involved adding one or two drops of a 2% FeCl3 solution to 2 ml of glacial acetic acid mixed with crude extract. This mixture was then placed in a test tube. A second test tube was prepared with the same combination, along with 2 ml of concentrated H2SO4. The formation of a brown ring at the interface between the two layers indicated the presence of cardiac glycosides (RNS and Munin, 2011; Nagy Morsy 2014; V. Nandagoapalan et al., 2016; Maryam Jamil et al.,2012).
B. Legal’s Test
A single milliliter of the extract is combined with Sodium nitroprusside in pyridine and Sodium hydroxide. The development of a colour ranging from pink to deep red suggests the existence of Carberolide. (Nagy Morsy, 2014).
2.3.2. Examination for Alkaloids
- Wagner’s test
A mixture of leaf extract (approximately 1 ml) and Wagner's reagent, which is a diluted iodine solution, is prepared. The formation of a brown precipitate in this mixture indicates the presence of alkaloids. (V. Nandagcapalan et al., 2016; Nagy Morsy, 2014; k. Sahira Banu et al., 2015).
- Mayer’s test
When a sample solution is exposed to Mayer's reagent (composed of potassium mercuric iodide), it produces a cream-colored precipitate. This reaction suggests the presence of alkaloids in the sample. (Nagy Morsy, 2014; Vishnu Balamurygan et al., 2019; K. kabesh et al.,2015).
- Hager’s test
When the acetic test solution is combined with Hager's reagent, which is a saturated picric acid solution, it produces a yellow precipitate. This reaction indicates the presence of alkaloids in the sample. (Nagy Morsy, 2014).
2.3.3. Exammation for steroids
- chloroform test
In a test tube, 1 mg of the raw plant extract was combined with 1 ml of chloroform. An equivalent amount of concentrated sulfuric acid was then added. The resulting layer exhibited a yellow colour with green fluorescence, indicating the presence of steroids (RNS Yadav et al., 2011).
- Salkowski's test
The second portion of the solution was carefully combined with concentrated sulfuric acid to create a bottom layer of acid. The boundary between the two layers was then examined for the presence of a reddish-brown coloration, which would indicate the existence of a steroid ring (Nagy Morsy, 2014).
2.3.4 Examination for Terpenoids
a. Liebermann Burchard test
To detect the presence of terpenoids, a specific test is conducted. The procedure involves adding a few drops of acetic anhydride to the test solution and mixing it thoroughly. Subsequently, concentrated sulfuric acid is carefully poured down the sides of the test tube. If terpenoids are present, a brown ring forms at the interface of the two layers, and the upper layer turns green (Maryam et al., 2012).
2.3.5 Examination for phenol
a. Ferric Chloride Test
A Small amount of the ethanolic extract Was taken with 1mL of Water in a test tube and 1to2 Drops of Iron III Chloride (Fecl3) Was added A Blue, Red or Purple Colour is a Positive test (K. kabesh et al., 2015; RNS Yadav edal.,2011).
2.3.6 Examination for saponins
a. froth Test
When combined with water and shaken, the crude dry powder extract of saponins produces foam that remains stable for a minimum of 15 minutes. (Nasy Morsy, 2014; Vishnu Balaminugan, 2019).
2.3.7 Examination for Carbohydrates
a. Molisch's test
the presence of carbohydrates is indicated when the test solution is combined with a few drops of Molisch's reagent and 2 ml of concentrated sulfuric acid is carefully added along the sides of the container, creating a junction between the two liquids (RNS Yadav et al., 2011; K. Sahira Banu et al., 2015).
- Benedict's Assay
A sample solution subjected to Benedict's reagent and heated in a water bath produces a reddish-brown precipitate, indicating the presence of carbohydrates (RNS Yadav2011; k. Sahira Banu et al., 2015).
2.3.8 Examination for phenol
a. Ferric chloride Test
A small quantity of the ethanolic extract was mixed with 1 ml of water and a couple of drops of iron III chloride (Fecl3) in a test tube. The presence of a blue, green, red, or purple color in the test results indicates a positive outcome (K. kabesh et al., 2015; RNS Yadav et al., 2011).
2.3.9 Examination for proteins
a. Millon’s Test
When a sample is mixed with Millon's reagent and warmed in a water bath, the appearance of a yellow color indicates the presence of proteins. This test involves heating the solution and observing the resulting stain, which serves as a marker for protein detection (Nagy Morsyo, 2014; RNS Yadav et al., 2011).
b. Ninhydrin test
The test solution turns blue after being treated with ninhydrin reagent shows that proteins are present (Nagy Morsy, 2014; RNS Yadav et al., 2011).
2.4. Pharmacological Analysis
2.4.1 Anti-oxidant activity using the 2,2-di- Phenyl-1-picryl hydrazyl (DPPH) assay.
Antioxidants are substance that can neutralize free radicals which are Unstable molecules that damage cells. Oxidants cause various health issues like cancer (Chandra Risdian et al., 2011). the free radical scavenging activity of the ethanolic leaves extract of Piper betle Linn (Chandra Risdian et al., 2011). Stock solution Contain of DPPH and 1 ml of plant extract (various Concentration like 200, 400, 600, 800, 1000 ug/ml). Ascorbic Acid Used in positive Control or standard (Devjani Chakraborty et al., 2011). Allow the reaction mixture to incubate for 30 minutes at 37°C under dark conditions. Following the incubation period, determine the absorbance at 530 nm. The DPPH free radical scavenging activity percentage can be determined using the subsequent equation (KY pin et al., 2010). The percentage of inhibition can be calculated using the following formula: [(control absorbance - test absorbance) / control absorbance] x 100.
2.4.2 Anti-inflammatory effects assessed via Protein Denaturation Assay.
Inflammation is the response seen after cellular damage resulting in the formation of a protein rich exudate. This process is a component of innate immunity, characterized by symptoms such as pain, heat, redness, swelling, and impaired function (Rintu D et al., 2015). The concept of protein denaturation refers to the disruption and unfolding of a protein's secondary and tertiary structures without breaking or hydrolyzing peptide bonds (puspal De et al, 2017). the reaction mixture contains 0.4ml of egg albumin and 5.6ml of 6.9 PH PBS (phosphate buffer saline). further add 1ml of various concentration of plant extract and standard Diclofenac Sodium. Allow the reaction mixture to sit for 5 minutes at room temperature, then heat it to 70°C for 15 minutes. Once the incubation is complete, let the mixture cool down and determine its absorbance at 530 nm. The percentage of protein denaturation inhibition can be calculated using the formula provided (P.R. Abishek Nadig et al., 2021). The percentage of inhibition can be calculated using the following formula: [(control absorbance - test absorbance) / control absorbance] x 100.
2.4.3 Antibiofilm assay
It Involves The ability to inhibit the formation and stability of Bacterial Biofilm. this is typically Done by Exposing biofilm structure, biofilm viability, Common methods Include crystal violet staining, Microscopy and Quantification of biofilm Associated factors. The experimental setup consists of combining 2ml of nutrient broth, 10 µl of bacterial suspension, and 50 µl of varying concentrations of plant extract and Standard Streptomycin in sterile conditions. This mixture is then incubated at 37°C for 24 hours. The following day, remove the reaction mixture and add 1ml of 0.1% Crystal violet Stain. Allow the mixture to incubate at room temperature for 10 minutes. Subsequently, discard the stain and introduce 70% ethanol. Measure the absorbance at 560 mm. The biofilm inhibition percentage is determined using the formula (SULTANA RAJIA et al, 2021):
The percentage of inhibition can be calculated using the following formula: [(control absorbance - test absorbance) / control absorbance] x 100.
2.4.4 Antifungal assay
The widespread use of broad-spectrum antibiotics and immunosuppressive treatments has led to a significant clinical problem: fungal infections. Candida stands out as the most prevalent among all fungal species (Rattiporn et al., 2018). To prepare Sabouraud dextrose agar media, combine the necessary components and sterilize in an autoclave at 121°C for 15 minutes. Subsequently, pour the media into petri plates according to the required well sizes. Spread 100 µl of bacterial suspension evenly across the growth medium. Create 6 mm diameter wells using a cork borer. Add the standard to the designated well. Place the plates in an incubator at 37% for 24 hours. Following successful incubation, examine and measure the zone of inhibition.
2.4.5 Antibacterial assay
Antibacterial is a suppresses their bacterial growth using the well diffusion Method involves introducing antibacterial Substances into wells on an agar plate (K. Kabesh et al., 2015). Prepare the nutrient agar media by using media Components. Sterilize the prepared growth media in an autoclave at 121°C for 15 minutes. Distribute the media into petri dishes according to the required well sizes. Spread 100 µl of bacterial suspension evenly across the growth medium. Create wells with a diameter of 6 mm using a cork borer. Introduce the standard streptomycin and test sample into their respective wells. Place the plate in an incubator set at 37°C for a period of 24 hours. After the successful incubation Observe and Measured the zone of Inhibition.
2.4.7 Antihelminthic assay
Parasitic worms & infect crops, domestic pets and livestock and affecting food production with an economic impact (sonalkar et al., 2017). Antihelminthic assay involves evaluating Substances with for their ability to inhibit or kill parasitic helmintics. This is typically done by exposing helminthics to the test Substance and assessing parameters such of motility, viability or Structural integrity, aiming to identify Compounds with Antihelmintic properties for the treatment of parasitic worm infections. Take two petri dishes with lids and label it has Standard and test. Wash the earthworms with the help of Distilled water takes Earthworm each plate. Pour the 20 ml of Standard and sample in respective petri plate. Using a stopwatch, record the duration of paralysis and the time of death for each earthworm.
3. RESULTS AND DISCUSSION
This research examined the phytochemical, antimicrobial, and pharmacological properties of Piper betle Linn leaves. The investigation yielded several findings.
3.1 Phytochemical examination
Beyond determining the constituents of plant extracts and which element is most prevalent among them, phytochemical analysis has been shown to be helpful in identifying glycosides, alkaloids, flavonoids, steroids, Terpenoids, saponins, phenol, carbohydrates, proteins that can be utilized in the synthesis of therapeutic agents. The phytochemical screening of Piper betle Linn indicated the presence of steroids, terpenoids, glycosides, proteins, and flavanols, while saponins, carbohydrates, alkaloids, and phenol were found to be absent (Table 1).
3.2 Anti-oxidant activity using the 2,2-di- Phenyl-1-picryl hydrazyl (DPPH) assay.
The DPPH assay is a widely used technique for evaluating a substance's capacity to donate hydrogen or neutralize free radicals. It is also useful for determining the antioxidant qualities of different foods. It is recognized for its ease of use, rapidity, cost, and simplicity. The antioxidant properties of Piper betle Linn were evaluated using the DPPH assay (Figure 1). In This Plant the Antioxidant activity at Concentration 200 µg/ml was Higher Percentage of Inhibition as Compare to Other Concentration. Antioxidants in complex biological systems can also be measured using this technique, which accepts both liquid and solid materials.
3.3 Anti-inflammatory effects assessed via Protein Denaturation Assay
The theory underlying the protein denaturation assay is that compounds with anti-inflammatory qualities can stabilize protein structures, hence blocking denaturation, a process that is frequently connected to tissue damage and inflammation. A protein denaturation assay was performed to evaluate Piper betle Linn anti-inflammatory potential (Figure 2). In This Plant the Anti-inflammatory activity at Concentration 200 µg/ml was Higher Percentage of Inhibition as Compare to Other Concentration.
3.4 Antibiofilm assay
The Antibiofilm assay of Piper betle Linn was tested using an Antibiofilm assay (Figure 3). In This Plant the Antibiofilm assay at Concentration 200 µg/ml was 100 % i.e. Higher Percentage of Inhibition as Compare to Other Concentration.
3.5 Antifungal assay
The primary purpose of the antifungal assay is to assess how effectively the plant extract can inhibit or regulate fungal growth, thereby preventing the development of fungi. Piper betle Linn antifungal capability was assessed (Table 2 and figure 4). Candida albicans were used for antifungal assay. In This Plant the Antifungal assay was Compare to Standard and Test Sample. The Test Sample was High Inhibit to fungi.
3.6 Antibacterial assay
An extract’s ability to stop germs from growing is known as its antimicrobial activity. Plants, animals, and humans are all infected by these microbes. Piper betle Linn demonstrated effective antibacterial properties. We conducted an antimicrobial assay to assess the antibacterial efficacy of Piper betle Linn (Table 3 and figure 5). E. Coli was utilized to test the antibacterial effects. In This Plant the Antifungal assay was Compare to Standard and Test Sample. The Test Sample was Low Inhibit to Bacteria.
3.7 Antihelmintic assay
The Antihelmintic assay of Piper betle Linn was tested using an Antihelmintic assay (Table 4). In this experiment, an earthworm was utilized.
CONCLUSION
the Results obtained in this study of piper betle Linn Contain phytochemical such of Glycosides, Alkaloids, flavonoids steroid, Terpenoids, phenol, saponins, proteins. piper betle Linn have the ability to Shows Antimicrobial, Antifungal, Antihelmintic, Antibiofilm Ant-immflammatory, Antioxidant activity. the herb Piper betle Linn exhibits significant potential of a source of pharmacological components that combat a range of infections. piper belle Linn is known to offer numerous Heath benefits Including aiding in proper digestion, preventing diseases, and controlling. the harmful oxidants. Incorporating it into daily meals can be highly beneficial and act as an enhancer for the human population. the current study demonstrates impressive results for piper betle Linn extracts. Based for on our findings from the current study, we concluded that piper betle Linn possesses medicinal properties and can be Used to treat and prevent various infections Additionally, research is necessary to comprehensively investigate the potential therapeutic applications of piper betle Linn.
ACKNOWLEDGMENT
The work was supported by Mr. Masidd Khalate, Director of Infinite Biotech Institute of Research and Analytics, Sangli by Ministry of Micro, Small and Medium Enterprises (MSME): UAM-MH-29-0041333 Registered Under State Research Shop Act MH-108066802203.
Declarations:
Ethics Approval: This is an observational study. The Infinite Biotech Institute of Research and Analytics Research Ethics Committee has confirmed that no ethical approval is required. This research article does not Contain any Studies with Human Participants or animals performed of this Manuscript.
Consent to Participate: Informed Consent was obtained from all individual participants included in the Study.
Author Contributions: Darshan: Conducted experiments and Wrote the Manuscript, Ashwin: analysed the Data, Aishwarya: Reviewed the Manuscript, Pranoti: Conceptualization and Finalized the Manuscript.
Funding: The authors declare that no funds, grants, or other support were received during the preparation of this manuscript.
Competing Interests: The authors have no relevant financial or non-financial interests to disclose.
Availability of data and Materials: Available on data.
REFRENCES
-
-
-
- Sushma s. kumar, sona v. pauly, Sowmya. Shree Ct. Phytochemical screening of Inflorescence of piper betle. International Journal of current pharmaceutical Research, 2020;12(6):89-92.
- Chandra Risdian, wahyu, widowati, Tjandrawati Mozef, Teresa Liliana, wargasetia, Khie Khieng. Free Radial scavenging Activity of Ethanolic leaves Extract and its Different solvent fractions of piper betle L. In vitro. Indonesian Journal of cancer chemoprevention Feb 2011; 2(1): 141-145.
- Devjani Chakraborty, Barkha Shah. Antimicrobial, Antioxidative and Anti- Hemolytic Activity of piper betel Leaf Extracts International Journal of pharmacy and pharmaceutical sciences. 2011; 3(3)192-199.
- Gowhar Ahmand shah, Tajamul Islam shah, Sanjay Telang Evaluation of Bio Active Constituents and In-Vitro Antioxidant Activity of Different Extracts of piper betle L. Leaves 2015;4(8): 2259-2269.
- K S shivashankara, Tk Roy, G A Geetha. Antioxidant capacity, Radical Scavenging. Ability, total phenols and flavonoids in three types of betel vine (piper betle L) three Journal of spices and Aromatic crops 2012;21(1):64-67.
- K. Kabesh, P. jenthikumar, R. Ragunathan R. Rajkumar. Phytochemical Analysis of Catharanthus roseus plant Extract and its Antimicrobial Activity. Inter- national Journal of Pure and Applied Bioscience. 2015;3(2): 162-172.
- K. Sahira Banu, Dr. L. Cathrine. 2018 General Techniques Involved in phytochemical Analysis. International Journal of Advanced Research in Chemical science. 2015; 2(4):20-32.
- KY pin, A luqman chuah, an Abdull Rashif MP Mazura, J fadzureena, svimala and Ma Rasadah. Antioxidant and Anti-inflammatory Activities of. (Piper betle) Extracts of Betel leaves (piper betle) from Solvents with Different polarities. Journal of Tropical Forest science. 2010; 22(4): 448-455
- Maryam Jamil, Bushra Mirza, Abida Yasmeen, Mir Ajab khan pharmacological activities of selected plant species and their phytochemical analysis. Journal of Medicinal plants Research 2012;6(37): 5013-5022.
- Murni sundang, Sharifah Norfarahanisyed Nasir, coswald stephen Sipaut, Hasnah othman. Antioxidant Activity, Phenolic, flavonoid Tannin content of Piper betle and Leucosyke capitella Malaysian Journal of fundamental and Applied Sciences. 2012; 8(1):1-6.
- Nagy Morsy. Phytochemical analysis of biologically constituents of Medicinal plants, main Group chemistry. 2014; 7-21.
- Nishant M patel, Darshankumarp. Jain, Hemant p. suryawanshi, sunil p pawar Phytopharmacological &study of piper betle leaf. Saud, Journal of Medical and pharmaceutical Sciences 11.2019; 5(11): 964-971.
- P. R. Abhishek Nadig, Tej Ganapathy Mandira and J. R Kumar. Comparative studies on the Antioxidant, Anti- Inflammatory and Phytochemical constituents of paper betel from the western that’s and Northern Region of Karnataka. International Journal of pharmaceutical Sciences and Research.2021;12(6):1000-11.
- Parthasarathi perumal, kavitha saravanabhavan. AntiDiabetic and Antioxidant Activities of Ethanolic Extract of Piper betle leaves in catfish, Clarias Gabrielinos. Asian Journal of Pharmaceutical and Clinical Research 2018, 11(3):194-198.
- Puspal De, subhradeep sorkar, Madhumita J, Mukhopadhyay, Anti protein denaturation activity and bioactive compound screening of piper betle aqueous and alcoholic leaf extract Journal of Pharmacagnosy and phyto chemistry. 2017; 6(2): 52-55.
- Rattiporn kaypetch, sroisiri Thaweboon. Antifungal property of piper betle leaf oil against oral candida species. MATEC web of Conferences 242. 2018;1-4.
- Rintup, Shinjini M. Kaustab M, pramathadhip P. Umesh and Bomerjee. Anti-oxidant and Antinflammatory Activities of Different varieties of piper Leaf Extracts (Piper Betle L.) Nutrition. And food sciences. 2015;5(5) 11-15.
- RNS Yadav, Mumin Agarwala. Phytochemical analysis of some Medicinal plants. Journal of phytology. 2011;5(12):10-14.
- S. E. Abah, L.o. Egwari. Methods of Extraction. And Antimicrobial susceptibility testing of plant Extracts. African. Journal of Basic and Applied Science, 2011; 3(5):205-209.
- Sapara sekhar Harini, pagadalar sougandhi, Tenkayala Shobha Rani, kamalamma Ramalingam Gopinath. Antioxidant Activity (Phenol and flavonoid Content) of three Different Cultivars of piper betle. (Piperaceae). 2018; 8(5) 143-148.
- sarabjot kaur, poonam mondal. Study of Total phenolic and flavonoid content, Antioxidant Activity and Antimicrobial properties of medicinal plants, Journal of Microbiology and Experimentation.2014;1(1):1-6.
- Sonalkar M.Y, Nitaves. A. Comparative Anthelmintic Activity of piper belle Linn and Moringa oleifera. World Journal of pharmacy and pharmaceutical sciences. 2018; 7(1):1530-1535.
- Subash kumar, R., M. suresh kumar, S. Babu and Tha. Thayumanavan. Antibacterial effect of crude aqueous extract of piper betle L. against pathogenic bacteria. International Journal of Research in pharma- ceutical and Biomedical sciences, 2013;4 (1):42-46.
- Sultana Rajia, khadiza, khanam, Vmme Farhana, Sohanur Rahman, Rashidul Haque. Piper Chaba extracts with Antibiofilm Activity Influence. Antihyperalycemic and Antihyperlipidemic Responses in Diabetic wister Rats. International Journal of pharmacy and pharma ceutical sciences, 2021; 13(9): 44-43.
- V. Nandagaapalan, A. Doss, C. Morimuthu. Phytochemical Analysis of some traditional Medicinal plants. Bioscience Discovery. Jam 2016;7(1):17-20.
- Vandana Dwivedi, shalini Tripathi. Review. study on potential activity of piper betle. Journal of pharmacognosy and phytoChemistry, 2014;3(4):93-98.
- Vishnu Bulamurugan, sheerin fatima, MA, Sreenithivelurajan. A Guide to phytochemical Analysis, I JARIE. 2019;5(1):286-245.


 Darshan Hosmath*
Darshan Hosmath*
 Ashwin Satale
Ashwin Satale
 Aishwarya Salunkhe
Aishwarya Salunkhe
 Pranoti Mali
Pranoti Mali

10.5281/zenodo.15038704
10.5281/zenodo.15038704